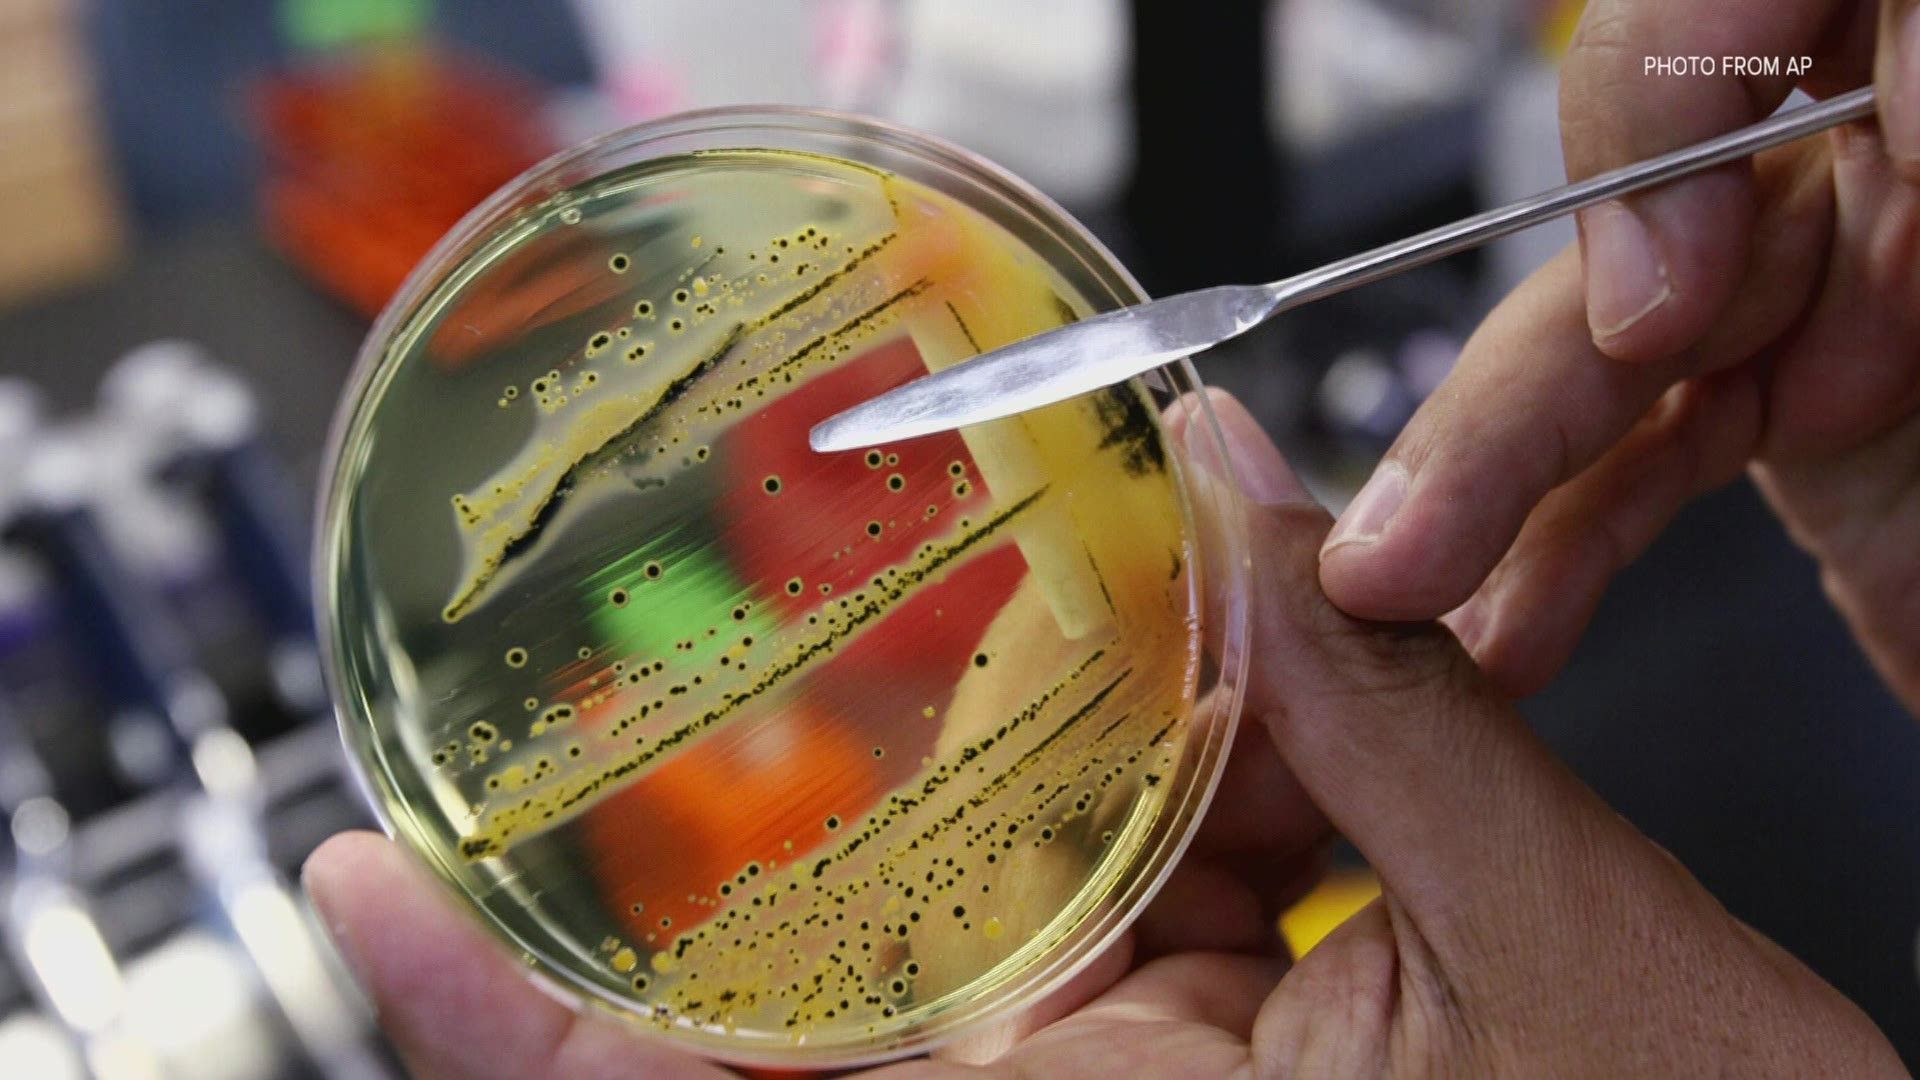

Si ta luftoni bakterin “Escherichia coli”?
Merret nëpërmjet marrëdhënieve seksuale, për shkak të higjienës së keqe, prostatës së zmadhuar dhe mbajtjes së urinës
Shkakton infeksionin e rrugëve urinare dhe të traktit të zorrëve, por edhe inflamacionin e tëmblit, hematoksi të rëndë, transmeton Telegrafi.com.
Infeksionet bakteriale mund t’jua bëjnë të rëndë jetën. Shkaktojnë vështirësi të cilat krijojnë nervozë, ndërkaq kur gjejnë vend të përshtatshëm për t’u shumëzuar, nuk eliminohen lehtë.
Nëse nuk shërohen me kohë, mund të shkaktojnë komplikime serioze.
Escherichia coli është njëra ndër bakteret më të rënda, ndërkaq shumica as pas luftimit shumëvjeçar me barna, çaje dhe me preparate të ndryshme, nuk mund të shërohen me sukses.
Gjëja kryesore në trajtimin e këtyre bakterieve është që të bëjë që ju të ruani rehatinë dhe të parandaloni përhapjen e saj.
Format e marrjes së këtij bakteri:
- Përmes konsumimit të ushqimeve apo ujit të kontaminuar
- Nëse jetoni afër ambienteve me bagëti
- Nga ushqimet si spinaqi, sallata, kastravecët dhe ushqimet e tjera me origjinë bimore që kultivohen me plehun e këtyre kafshëve
- Nga uji i ndotur
- Nga mishi i pagatuar mirë, sidomos ai i ushqimeve të shpejta
- Konsumimi i frutave dhe perimeve pa u larë
- Lani mirë frutat dhe perimet
- Qëndroni larg bagëtive, sidomos fëmijët
- Zieni mishin mirë dhe mos e hani të pagatuar
- Tregoni kujdes me nënproduktet e kafshëve si qumësht, djathë, etj.
- Kujdesuni për higjienën tuaj
Zakonisht bakteri E coli nuk shkakton simptoma, pavarësisht se mund të ndodhet në zorrët tuaja. Në raste të tjera më të përkeqësuara ai shkakton diarre, e cila brenda pak orësh bëhet hemorragjike.
Simptoma të tjera mund të jenë koliti dhe dhembja e barkut. Duke qenë se dhimbjet janë shumë të forta, shpesh ky bakter ngatërrohet dhe me zorrën e verbër.
Zakonisht diarreja e shkaktuar nga bakteri E coli zgjidhet brenda 4-5 ditëve. Në rast se helmi qarkullon më gjatë, ai mund të shkaktojë anemi dhe insuficiencë renale.
Për fat të keq nuk ka kurë specifike, terapia me antibiotikë, ashtu si me gastroenteritet nuk është efikase, madje mund të përkeqësojë situatën.
"Nëse shkatërrohen bakteret me antibiotikë, atëherë lirohen më shumë qeliza helmuese dhe ashpërsohen simptomat. Pra kjo është absolutisht kundërproduktive. Dhe kjo është arsyeja pse antibiotikët për fat të keq nuk janë në asnjë mënyrë mundësi e terapisë për rastet me infeksionet EHEC", thonë mjekët.
Prandaj mjekëve nuk u mbetet tjetër veç mundësisë për të zbutur simptomat. Në këtë mes ndihmojnë infuzionet, të cilat kompensojnë humbjen e lëngjeve te pacientët, te pacientët me simptoma të rënda, pastrimi i gjakut përmes dializës mund të parandalojë dëmtimin e përhershëm të veshkave. /Telegrafi/